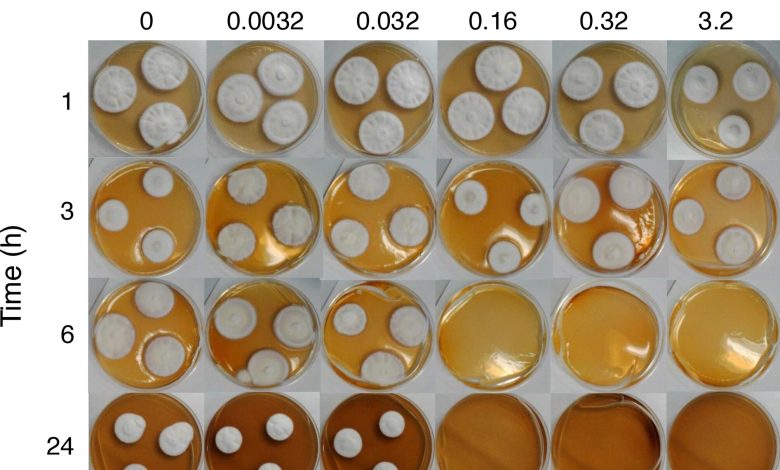

Gás de ‘ovo podre’ pode ser a resposta para tratar infecções nas unhas, dizem cientistas

Efeito de H2Tempo de exposição e concentração de S contra T. rubrum. Placas de ágar foram inoculadas com 3 manchas de T. rubrum ATCC 28.188, incubadas em caixas herméticas por 1, 3, 6 e 24 horas, na presença de diferentes concentrações de H2S, seguido por uma nova incubação sem H2S por mais 7 dias. As concentrações H2S indicados são aqueles que seriam alcançados se todo o sulfeto disponível fosse liberado como H gasoso2S. Crédito: Relatórios Científicos (2025). DOI: 10.1038/s41598-025-22062-7
O sulfeto de hidrogênio, o gás vulcânico que cheira a ovo podre, poderia ser usado em um novo tratamento para infecções complicadas nas unhas que atua mais rápido e com menos efeitos colaterais, de acordo com cientistas da Universidade de Bath e do King’s College London (KCL).
A pesquisa está publicada em Relatórios Científicos.
As infecções nas unhas são causadas principalmente por fungos e, ocasionalmente, por bactérias. São muito comuns, afetando entre 4 e 10% da população mundial, atingindo quase metade das pessoas com 70 anos ou mais. Estas infecções podem levar a complicações, especialmente em grupos vulneráveis, como diabéticos e idosos, mas são notoriamente difíceis de tratar.
Os tratamentos atuais incluem antifúngicos orais tomados em forma de pílula e tratamentos tópicos aplicados diretamente na unha. Os antifúngicos orais levam cerca de 2 a 4 meses para agir e são razoavelmente eficazes, mas apresentam riscos de efeitos colaterais, especialmente em pacientes com outras condições médicas.
Os tratamentos aplicados diretamente na unha são mais seguros, mas muitas vezes demoram muito mais para fazer efeito, às vezes até anos para fazer efeito, e frequentemente recaem ou falham. Isso ocorre principalmente porque é muito difícil fazer com que o medicamento penetre através da unha até onde reside a infecção.
Mesmo os tratamentos tópicos mais eficazes têm taxas de cura relativamente baixas, pelo que existe uma clara necessidade de novas abordagens terapêuticas que sejam seguras, eficazes e capazes de atingir micróbios profundamente inseridos na unha.
Uma equipe da Universidade de Bath e do King’s College London descobriu agora que o sulfeto de hidrogênio (H₂S), um pequeno gás que ocorre naturalmente, poderia ser desenvolvido em um novo tratamento promissor.
Trabalhos anteriores mostraram que penetra na lâmina ungueal de forma muito mais eficiente do que os medicamentos tópicos existentes, e agora a equipa demonstrou que tem uma forte actividade antimicrobiana contra uma vasta gama de agentes patogénicos das unhas, incluindo fungos que são resistentes aos tratamentos antifúngicos comuns.
Em testes de laboratório, a equipe utilizou um produto químico que se decompõe para liberar o gás sulfeto de hidrogênio e descobriu que ele atua de maneira única, interrompendo a produção de energia microbiana e provocando danos irreversíveis, acabando por matar os fungos.
Albert Bolhuis, do Departamento de Ciências da Vida da Universidade de Bath, disse: “Graças à sua capacidade de atingir eficientemente o local da infecção e ao seu novo modo de ação, acreditamos que um medicamento aplicado topicamente contendo sulfeto de hidrogênio poderia se tornar um novo tratamento altamente eficaz para infecções nas unhas, o que evita as limitações das terapias atuais.
“Nossa pesquisa estabelece as bases para uma alternativa atraente aos tratamentos existentes, com potencial para melhorar os resultados para pacientes que sofrem de infecções fúngicas persistentes e resistentes a medicamentos nas unhas”.
O sulfeto de hidrogênio é conhecido por seu cheiro pungente de ovo podre e tem alguma toxicidade. No entanto, os investigadores acreditam que as quantidades necessárias estão bem abaixo dos níveis de toxicidade e a formulação correta limitará quaisquer odores desagradáveis.
A pesquisa até agora só foi feita in vitro, mas a equipe espera desenvolver um tratamento que possa ser usado em pacientes nos próximos cinco anos.
O professor Stuart Jones, diretor do Centro de Pesquisa em Medicina Farmacêutica da KCL, disse: “Estamos ansiosos para traduzir essas descobertas em um produto tópico inovador que possa tratar infecções nas unhas”.
Mais informações:
Fritz Ka-Ho Ho et al, Efeitos antimicrobianos e mecanismos do sulfeto de hidrogênio contra patógenos ungueais, Relatórios Científicos (2025). DOI: 10.1038/s41598-025-22062-7
Fornecido pela Universidade de Bath
Citação: O gás ‘ovo podre’ pode ser a resposta para o tratamento de infecções nas unhas, dizem os cientistas (2025, 3 de novembro) recuperado em 4 de novembro de 2025 em https://medicalxpress.com/news/2025-11-rotten-egg-gas-infections-scientists.html
Este documento está sujeito a direitos autorais. Além de qualquer negociação justa para fins de estudo ou pesquisa privada, nenhuma parte pode ser reproduzida sem permissão por escrito. O conteúdo é fornecido apenas para fins informativos.






